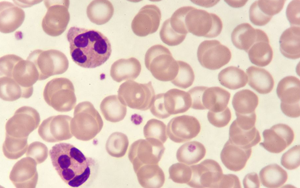

專業(yè)的團(tuán)隊(duì),提供整體解決方案
穩(wěn)轉(zhuǎn)細(xì)胞株服務(wù)
慢病毒常用于制備穩(wěn)定表達(dá)/沉默特定基因的單克隆細(xì)胞株。西寶生物擁有帶熒光標(biāo)簽的各種真核篩選抗性的慢病毒載體,能滿足幾乎所有的穩(wěn)轉(zhuǎn)細(xì)胞株構(gòu)建服務(wù)。詳情致電400-021-8158!

CRISPR-Cas9構(gòu)建服務(wù)
Cas9首先與crRNA及tracrRNA結(jié)合成復(fù)合物,然后通過(guò)PAM序列結(jié)合并侵入DNA,形成RNA-DNA復(fù)合結(jié)構(gòu),進(jìn)而對(duì)目的DNA雙鏈進(jìn)行切割,使DNA雙鏈斷裂;CRISPR-Cas9系統(tǒng)已經(jīng)成功應(yīng)用于植物、細(xì)菌、酵母、魚類及哺乳動(dòng)物細(xì)胞,是目前效率較高的基因組編輯系統(tǒng)。西寶生物提供CRISPR-Cas9構(gòu)建服務(wù),是目前效率較高的基因組編輯系統(tǒng),詳情致電400-021-8158!

染色質(zhì)免疫共沉淀技術(shù)(Chip)
染色質(zhì)免疫沉淀技術(shù)(ChIP,Chromatin Immunoprecipitation Assay)通過(guò)與染色質(zhì)片段共沉淀和qPCR技術(shù),在體內(nèi)檢測(cè)與特異蛋白質(zhì)結(jié)合的DNA片段。ChIP技術(shù)較大的優(yōu)點(diǎn)就是在活體細(xì)胞狀態(tài)下研究了蛋白質(zhì)和目的基因結(jié)合狀況,減少了體外實(shí)驗(yàn)的誤差。

細(xì)胞遷移實(shí)驗(yàn)
細(xì)胞Transwell實(shí)驗(yàn)將Transwell小室放入培養(yǎng)板中,小室內(nèi)稱上室,培養(yǎng)板內(nèi)稱下室,上下層培養(yǎng)液以聚碳酸酯膜相隔,將研究的細(xì)胞種在上室內(nèi),由于聚碳酸酯膜有通透性,下層培養(yǎng)液中的成分可以影響到上室內(nèi)的細(xì)胞,應(yīng)用不同孔徑和經(jīng)過(guò)不同處理的聚碳酸酯膜,就可以進(jìn)行共培養(yǎng)、細(xì)胞趨化、細(xì)胞遷移、細(xì)胞侵襲等多種方面的研究。

cDNA末端快速擴(kuò)增技術(shù)(RACE)
cDNA末端快速擴(kuò)增技術(shù)(rapid amplification of cDNA ends, RACE)是一種基于PCR從低豐度的轉(zhuǎn)錄本中快速擴(kuò)增cDNA的5'和3’末端的有效方法,以其簡(jiǎn)單、快速、廉價(jià)等優(yōu)勢(shì)而受到越來(lái)越多的重視。

熒光定量PCR服務(wù)
熒光定量PCR用TaqMan方法對(duì)DNA/RNA進(jìn)行realtimePCR的定量測(cè)定或型的鑒定。

多克隆抗體制備
提供多克隆抗體制備服務(wù)。我們有抗原設(shè)計(jì)軟件、獨(dú)特的免疫佐劑和獨(dú)特的免疫方案,特別擅長(zhǎng)小分子抗原的抗體制備,對(duì)于農(nóng)藥、小分子化合物、重金屬抗原的偶聯(lián)和免疫檢測(cè)具備獨(dú)到的核心技術(shù)。

新型M蛋白表達(dá)系統(tǒng)技術(shù)平臺(tái)
西寶生物開發(fā)出具有創(chuàng)新性的新型M表達(dá)系統(tǒng)技術(shù)平臺(tái)。本技術(shù)平臺(tái)為枯草芽孢桿菌蛋白表達(dá)系統(tǒng),擁有適用于分泌表達(dá)及胞內(nèi)表達(dá)的菌株以及對(duì)應(yīng)的多種表達(dá)載體,可以滿足不同表達(dá)需求。孢桿菌分泌的真核來(lái)源的重組蛋白具有天然構(gòu)象和生物活性,避免形成包涵體;表達(dá)周期短,蛋白產(chǎn)率高。

雜交瘤懸浮培養(yǎng)抗體制備服務(wù)
基于穩(wěn)定細(xì)胞系構(gòu)建和雜交瘤懸浮培養(yǎng)技術(shù),西寶生物提供大規(guī)模雜交瘤懸浮培養(yǎng)抗體制備服務(wù),滿足客戶快速大量獲得抗體的需求。詳情致電400-021-8158。

腺病毒包裝
腺病毒是分子細(xì)胞生物學(xué)實(shí)驗(yàn)很常用的基因表達(dá)工具,高侵染率使其成為動(dòng)物體內(nèi)表達(dá)基因的常用手段。pAdEasy是目前很成熟和流行的腺病毒構(gòu)建包裝系統(tǒng)。西寶生物為客戶提供速度更快,質(zhì)量更好的腺病毒包裝服務(wù)。
本網(wǎng)站銷售的所有產(chǎn)品僅用于工業(yè)應(yīng)用或者科學(xué)研究等非醫(yī)療目的,不可直接作用于人體或動(dòng)物,非藥用,非食用。